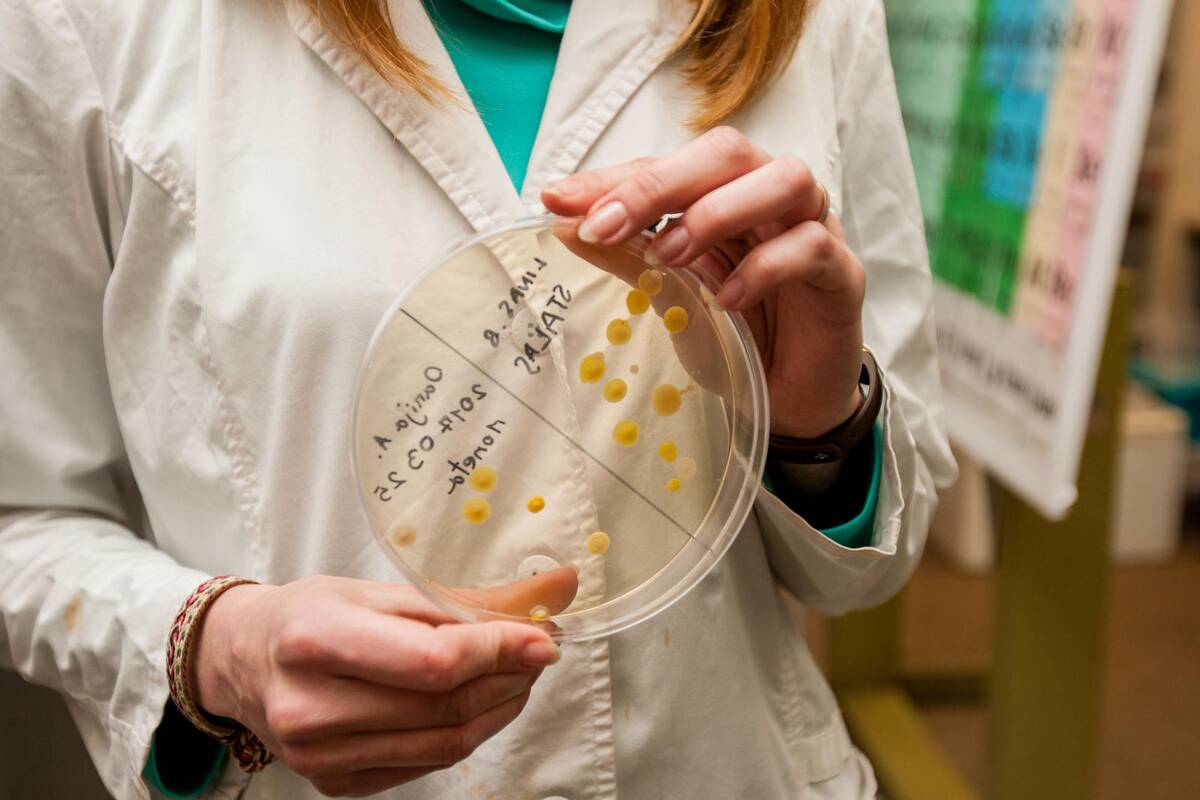

Rado aukso vidurį
Chemijos pamokų metu iš stiklinių kolbų virstantys garų kamuoliai ir ugnies liežuviai – praeitis. Daugumoje šalies mokyklų laboratorijų neliko nė kvapo, o vyresniųjų klasių moksleivių galvos kemšamos tik sausa teorija. Esą sudėtingų formulių gliaudymas, o ne praktikos įgūdžiai bus vertinami baigiamųjų egzaminų metu.
"Maža to, nuolat girdime, kad chemija, fizika ar biologija įkandama maždaug nuo 7–8 klasės, – Kauno tvirtovės VII forto direktorius Vladimiras Orlovas griovė šalies švietimo sistemai patogius mitus. – Netiesa. Chemija, fizika ir biologija prieinami nuo pirmos klasės. Svarbiausia rasti tinkamą metodą."
Regis, forto laboratorijos išradėjams tai pavyko padaryti. Edukacinius gamtos ir tiksliųjų mokslų užsiėmimus lankantys trečiokai be didelių sunkumų geba įrodyti Pitagoro teoremą ar surinkti elektros grandinę.
"Viena – kai tu matai, kita – kai pats darai", – prasitarė V.Orlovas, jau ne vienus metus besiremiantis metodu, kuris sujungė du skirtingus požiūrius – klasikinį ir projektinį. Pastarasis atkeliavęs iš Jungtinių Amerikos Valstijų, pagrįstas posakiu, esą žinios, kurių negalima parduoti, yra nieko vertos. Tuo metu antrasis kritikuoja praktiką ir aukština fundamentalias žinias.
"Mes sutinkame, kad tiesos yra pirmasis požiūris. Lygiai taip pat pabrėžiame, kad net maža praktika reikalauja didelės teorijos, o norėdami laužyti taisykles, jas turite gerai išmokti", – rastu aukso viduriu džiaugėsi V.Orlovas.
Kasdieniai bandymai
Forto kazematuose nerasite įrenginių, kurie stovi moderniausiose pasaulio laboratorijose. Čia negimsta ir didieji išradimai, keičiantys žmonių gyvenimus. Tačiau kone kasdien buvusiose kareivinėse sukasi dešimtys smalsių vaikų ir jaunuolių, bandančių išnarplioti gamtos ar tiksliųjų mokslų labirintus.
"Viskas prasideda nuo pačių paprasčiausių dalykų, kurie nereikalauja didelių išlaidų", – į kompaktinio disko dėklą lange pirštu bedė V.Orlovas. Pačiame jo centre – pipete kasdien drėkinama servetėlė ir agurko sėkla, kurios dygimą gali stebėti jaunieji biologai.

"Paklausęs, rytuose, vakaruose, šiaurėje ar poetuose geriausiai dygsta sėkla, vienas moksleivis dabar pats ieško atsakymo. Kaip? Labai paprastai. Suklijavęs sėklas skirtingų krypčių languose stebi, kuri jų greičiau šaknis leidžia", – su šypsena apie kasdienius jaunųjų eksperimentatorių ieškojimus kalbėjo VII forte įsikūrusio muziejaus vadovas.
Kiek tolėliau nuo stebuklingos sėklos, ant plačios palangės, maistiniais dažais spalvintu vandeniu troškulį malšino keturi salotų lapai. Vienas jų oranžinis, kitas – mėlynas, trečias – intensyviai žalias, o ketvirtas toks, kokį gamta sukūrė.
"Mokykloje veikiausiai būtų pasakyta tik tiek, kad augalas turi kapiliarus. Mes tai parodome pavyzdžiais iš gyvenimo", – į spalvų gamą mojo pašnekovas.
Mokykloje veikiausiai būtų pasakyta tik tiek, kad augalas turi kapiliarus. Mes tai parodome pavyzdžiais iš gyvenimo.
Skrodžia anatominę medžiagą
Spustelėjęs virdulio mygtuką, V.Orlovas palaukė, kol vanduo užkaito iki 80 laipsnių ir juo užpylė dubenėlyje esančius grūdelius, iš kurių gaminami chirurginiai siūlai. Jau po kelių sekundžių šie tapo permatomi ir minkšti.
"Dabar galima lipdyti ką tik norite", – mikliais rankų judesiais suformavęs meškiuką, V.Orlovas jį įmetė į šaltą vandenį ir liepė stebėti tolesnį procesą.
Kol šis pamažu keitė savo spalvą, baltais chalatais apsigaubusios laborantės iš šaldytuvo atnešė lėkštutę su vištų ir putpelių kiaušiniais, daugiau nei parą mirkytais maistiniame acte.

"Dabar jie primena guminius saldainius, be to, puikiai matyti visa sandara", – pirštų galais spustelėjusi tos dienos užsiėmimų vaizdinę priemonę, Vaiva Kulikauskienė vėl atvėrė šaldytuvo duris. Kyštelėjome nosį vidun. Šalia pieno pakelio stovėjo ananasų sultys. Vienu aukštu žemiau – tirštintas, saldintas pienas ir maišelis špinatų.
"Nežinau, ar norėsite pamatyti šaldiklio turinį, – ištraukęs apledėjusį stalčių su anatomine medžiaga joje, V.Orlovas stebėjo besimainančius mūsų veidus. – Kai reikia atlikti žiurkių skrodimą, panašiai reaguoja pusė merginų, svajojusių studijuoti mediciną. Staiga jos prisimena, kad neblogų specialybių yra ir Vytauto Didžiojo ir Kauno technologijos universitetuose."
Mūsų laimei, šaldiklio turinio tąsyk laborantės nejudino. Iš tolimiausios šaldytuvo lentynos paėmė tik kraujo mėginius. Juos naudoja vyriausi edukacinių programų dalyviai – vienuoliktokai ir dvyliktokai.
Už simbolinę kainą
Forte apstu ne tik priemonių, kurias nesunkiai rastume savo virtuvėje ar rašomojo stalo stalčiuje. Laboratorijoje stovi įranga, dar visai neseniai tarnavusi pasaulio šalių mokslininkams ir atradėjams.
"Štai šis aparatas prieš kelis mėnesius atkeliavo iš Vokietijos, – į maždaug 8 tūkst. eurų kainuojantį termostatą, kuris forto laborantams atiteko už simbolinę kainą, dirstelėjo V.Orlovas. – Turtingos laboratorijos dažniausiai būna sudariusios sutartis su pačiais garsiausiais gamintojais, todėl vos tik pasirodžius naujiems modeliams, šie keliauja į laboratorijas. Beje, "nauji" dažniausiai reiškia tik spalvotą ir liečiamą ekraną, o techniniai duomenys lieka tie patys."

Atkeliavus pamainai, senieji įrenginiai dažniausiai keliauja į metalo laužynus. Ten greičiausiai savo dienas būtų baigusi ir interaktyvi matematinė lenta iš vienos Anglijos mokyklos, dabar ji sėkmingai moko jaunuosius matematikus.
"Manoma, kad visa aparatūra gali tarnauti ne ilgiau kaip trejus metus. Todėl suėjus terminui tėvai perka naujas", – naująja mokymo priemone džiaugėsi V.Orlovas.
Tokiu pat keliu į fortą atkeliavo ir autoklavas – slėginis prietaisas, skirtas sterilizuoti.
"Šie įrenginiai mums atvėrė naujas galimybes. Tarkim, norint užauginti bakterijas, neretai reikia 37 laipsnių temperatūros. Palaikyti tokią šilumą kazematuose – neįmanoma. Lygiai taip pat neįmanoma su paprastu garpuodžiu idealiai sterilizuoti priemonių, naudojamų mūsų bandymuose", – šauniuosius pagalbininkus ranka plekšnojo V.Kulikauskienė.

Naujausi komentarai